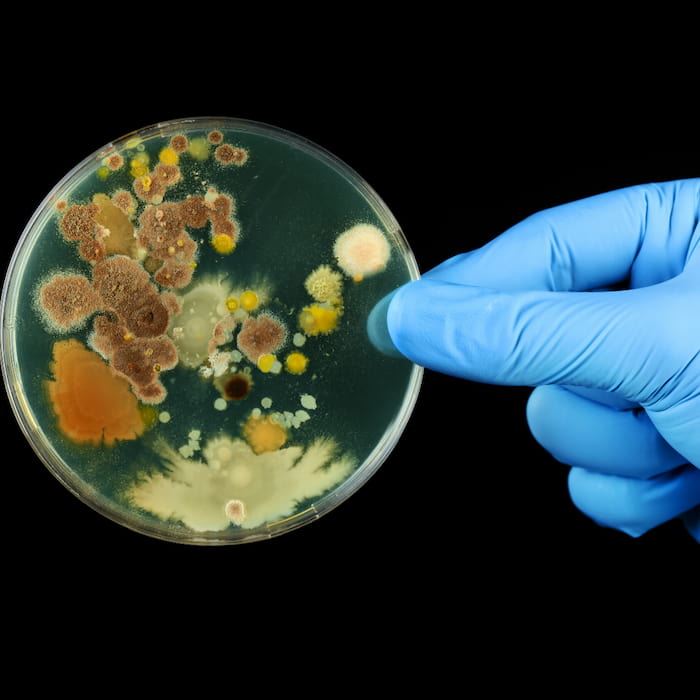

是不是感覺家裡的水臭臭的?
很多人會發現自來水打開後,隱約好像有點臭臭的味道,
沒錯這真的是發臭了,而有的家庭自來水臭味甚至嚴重到會刺鼻。
這時人們通常會聯想到水塔一定有問題,
以超人處理過的案件經驗,
最終結果絕大部分都不是水塔的問題。
大家都知道自來水的處理過程中會加氯消毒,
且會維持適量的餘氯量,讓水供給到用戶端的過程不會滋生病菌,保障用水安全。
但氯是很容易揮發的,一但餘氯揮發後,自來水的抑菌能力就不見了,
這時的細菌就大量孳生,臭味當然就隨之而來了。
其實自來水中添加之氯量很低,大約只在0.4~0.6 ppm左右,
而輸送到用戶端的時候就更低了,因此用水量就成了關鍵,
如果正常使用,即保持新鮮水源,讓水中一直都氯,
就不大會發臭,但如果用水量少或長期不使用,
那水中滋生病菌的速度就會大幅上升,
最長見的就是家中客房廁所的水龍頭或馬桶,這都是不常使用的。
當客人使用時,是不是就會有刺鼻的臭味迎面撲來,
這就是自來水長期在水管內不流動,形成死水、細菌大量孳生所產生的臭味。

因為水管管路是互通的,這些帶有細菌的死水,
一定還會影響到正常使用的管路,
細菌隨著正常使用的管路經過水龍頭,供我們使用、飲用。
沒錯,當我們正常使用的水龍頭出水臭臭的,
那就是正受到這些死水管路的侵害,而我們的身體健康也是。